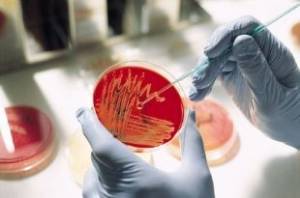

Состав и действие препарата
Капли в нос Синупрет содержат порошок сушеных лекарственных растений:
- корня горечавки;
- цветков первоцвета;
- травы щавеля;
- цветков бузины;
- вербены травы.
Состав может меняться в зависимости от формы выпуска препарата.
Лечебные свойства
Медикаментозное средство обладает ярко выраженным противовоспалительным действием. Его применение обеспечивает активное выведение слизистого или гнойного содержимого гайморовых пазух и носовых ходов. Систематическое использование препарата согласно инструкции по применению оказывает мощный противовирусный и иммуностимулирующий эффект.
Капли в нос Синупрет, используемые при хроническом рините вирусного или бактериального происхождения, способствуют переходу патологического процесса в стадию продолжительной ремиссии. Наряду с этим, компоненты лекарственного средства снижают ломкость сосудов и укрепляют местный, «носовой», иммунитет.
Поскольку капли Синупрет содержат натуральные элементы, которые хорошо воспринимаются организмом пациента, наряду с противовоспалительным, противовирусным и иммуностимулирующим действием, они:
- снимают отек тканей слизистых оболочек носа;
- купируют гиперемию носового эпителия;
- устраняют воспалительные процессы;
- стимулируют выведение гнойного или слизистого содержимого, что способствует полному очищению придаточных пазух носа;
- купируют патологические процессы и очищают от слизи нижние дыхательные пути (в частности, бронхи).
Таким образом, Синупрет оказывает комплексное воздействие на организм человека, за счет чего можно добиться максимального эффекта от терапии патологий носа в относительно короткие сроки.
Формы выпуска препарата
Следует сразу отметить, что такого препарата, как спрей в нос Синупрет, не существует. В аптеках имеется лекарство в форме аэрозоля «Синуфорте», но его нельзя путать с Синупретом.
Препарат Синупрет отпускается в форме:
- таблеток;
- драже;
- оральных капель;
- сиропа (для младенцев, не достигших годовалого возраста).
Причем таблетки считаются более эффективными, чем драже. А для лечения воспалительных процессов носа у ребенка целесообразнее всего применять капельки. Но перед покупкой лучше все же проконсультироваться с врачом. Он пропишет оптимальную форму препарата и его дозировку исходя из клинической картины заболевания.
Либо же перед приобретением тщательно ознакомьтесь с инструкцией по применению препарата, чтобы понять, можно ли употреблять лекарство вам или вашему ребенку.
Синуфорте или Полидекса — что лучше

В отличие от Синуфорте, Полидекса является комбинированным гормональным средством, обладающим противовоспалительным, сосудосуживающим и антибактериальным эффектами. Это антибиотик местного действия, который помогает пациенту справиться с гайморитом. В составе Полидексы неомицина сульфат, полимексин В сульфат, фенилэфрин, хлорид лития, лимонная кислота, макрогол.
Лекарственное взаимодействие аналога обусловлено содержанием фенилэфрина. Он снижает гипотензивное действие диуретиков и гипотензивных препаратов. Если нельзя избежать такой комбинации, то лечебный процесс аналогом должен осуществляться под наблюдением специалиста.
Средство запрещено использовать при болезнях почек, глаукоме, беременности и во время использования ингибиторов МАО.
Полезные свойства аналога заключаются в следующем:
- уменьшают воспаление;
- действуют на возбудитель синусита;
- приводят в норму дыхание;
- устраняют отек слизистой.
Средство назначают до 5 раз в сутки в зависимости от возраста человека. Курс терапии аналогом в отличие от оригинала составляет всего 10 дней.
Таблица — существующие формы препарата полидекса с ценами *
| ПОЛИДЕКСА 10,5МЛ КАПЛИ УШНЫЕ | ФАРМАСТЕР | Дексаметазон | 250.00 руб |
| ПОЛИДЕКСА С ФЕНИЛЭФРИНОМ 15МЛ НАЗ СПРЕЙ | Софартекс | Неомицин | 340.00 руб |
Синупрет или геломиртол что лучше
Рассматривая действие двух схожих препаратов, пациенты часто не знают, что выбрать, чтобы лечебный процесс наступил как можно быстрее. Стоит отметить, что геломирол является близким «по духу» препаратом в плане немецкого изготовления, растительной основы, разжижающего секрет действия, показаниях при синусите. Разница заключается в том, что препарат геломиртол имеет в составе растительные экстракты и выпускается в виде специальных капсул, оснащенных маслянистой жидкостью внутри. Как свидетельствуют отзывы пациентов, препарат имеет также несколько недостатков:
- Противопоказания при беременности и кормлении;
- Отсутствие возможности приема в случае конкрементов в желчном пузыре;
- Нельзя пить при наличии проблем с почками;
- Необходимость частого применения;
- Более высокая цена по сравнению с синупретом.

В прочих равных ситуациях именно синупрет выступает в качестве наиболее предпочтительного лекарственного препарата, поскольку обладает более широким эффектом.
Аналоги лекарственного средства Синупрет на основе парацетамола

Препараты на основе парацетамола назначают пациентам в составе комплексной терапии синуситов, ринитов, вирусных инфекций. Они не снимают воспаление, но облегчают общее состояние во время заболевания за счет жаропонижающего и обезболивающего действия.
После приема препаратов с содержанием парацетамола пациент чувствует облегчение при дыхании, носовые ходы становятся более свободными. Обволакивающее действие лекарства временно устраняет зуд, жжение, дискомфорт и боли в лобной и височной части головы. Применение жаропонижающих средств на ночь улучшает качество сна.
Список препаратов — аналогов:
- Колдрекс;
- Колдакт Флю Плюс;
- Колдфлю;
- Максиколд Рино;
- Аджиколд;
- Флюколд;
- Комбигрипп;
- Грипаут;
- Антигриппин;
- Терафлю;
- Фервекс;
- Хелпекс;
- Милистан.
Для лечения синусита фармацевтическая промышленность предлагает большой выбор лекарственных средств, аналогичных по своему действию с Синупретом, которые назначают как самостоятельно, так и в комплексной терапии. Химические препараты действуют быстрее, но натуральные средства более безопасны. Назначение лекарств зависит от возраста пациента, диагноза, степени течения болезни.
С осторожностью детям и беременным женщинам назначают аналоги Синупрет, которые производятся путем химического синтеза. Это связано с тем, что они имеют серьезные противопоказания и тяжелые побочные явления
А при передозировке могут вызвать симптомы отравления организма.
Популярные аналоги Синупрета
Существует достаточно много препаратов, которые могут использоваться как заменители Синупрета. Среди аналогов есть гомеопатические средства, синтетические и имеющие в основе природные компоненты.
1. Циннабсин

Этот препарат относится к гомеопатическим, и часто используется в качестве аналога Синупрета. Действие данного препарата направлено на снятие отечности и купирование воспаления. Кроме этого, данный аналог укрепляет иммунную систему. В числе показаний к назначению – синуситы.
Циннабсин обычно назначается для лечения ребенка с 12 лет, реже – с трехлетнего возраста. Во время беременности это средство может применяться только по назначению врача. Так как цена на Циннабсин в 2 раза выше, чем на Синупрет, то к дешевым заменителям его отнести нельзя.
2. Тонзилгон

Этот препарат имеет растительную основу и может использоваться при заболеваниях горла. А при синусите – в составе комплекса мер, как средство снятия воспаления. Препарат оказывает мягкое воздействие и применяется для лечения детей от 12 месяцев и беременных.
Тонзилгон, как аналог Синупрета, имеет список противопоказаний, включающий патологии печени, нарушения мозгового кровообращения и алкоголизм. Ценовая политика этого препарата находится в тех же пределах, что у Синупрета.
3. ГелоМиртол

Данное лекарственное средство является отхаркивающим. В составе этого аналога Синупрета присутствуют растительные компоненты, эффективные в отношении бактериальной инфекции и воспалений органов дыхательной системы. Этот препарат дает хороший муколитический эффект, способствует выведению слизи и очищению даже нижних отделов дыхательных путей.
Применение данного препарата имеет ограничение по возрасту (назначаться может только детям старше 10-ти лет). Во время беременности применять его в 1-ом триместре противопоказано.
К сведению! Кроме положительного действия, ГелоМиртол может вызывать побочные реакции со стороны ЖКТ, учащать пульс, стимулировать движение камней в почках и пр.
Выбор данного препарата или Синупрета должен осуществляться исходя из характера заболевания. При поражении болезнью нижних дыхательных путей лучше принимать первый из препаратов, при воспалениях в горле и носовых пазухах – Синупрет. ГелоМиртол считается аналогом препарата Синупрет, и стоит он немного дороже.
4. Синуфорте
В основе данного средства – экстракт цикламена. Назначением к применению Синуфорте являются те же состояния, что и при использовании Синупрета. Синуфорте, являясь аналогом, отличается быстрым эффектом.
Он практически сразу после применения очищает заложенные носовые ходы. При этом отхождение слизи и гноя из носовых пазух проходит обильно. Этот процесс может длиться от нескольких минут до часа. В результате происходит восстановление носового дыхания и улучшение общего самочувствия.
Цена на Синуфорте намного больше, чем стоимость Синупрета. В среднем она составляет порядка 1 300 рублей за флакон.
5. Назонекс
Снятие воспаления и аллергических реакций может быть проведено применением Назонекса. Этот препарат относится к группе кортикостероидов, выпускается в форме спрея.
Показаниями к его назначению подобного аналога Синупрета являются хронические формы синуситов. Назонекс может использоваться для лечения взрослых и детей от 12 лет в качестве средства вспомогательного действия.
6. Терафлю
Это лекарственное средство комплексного действия. Выпускается оно в Европе, Канаде и США. Терафлю (а также Терафлю Экстра) обладает хорошим противовоспалительным действием.
Препарат достаточно быстро купирует неприятные симптомы простуды и вирусной инфекции, воздействуя на носовые пазухи, горло, повышенную температуру тела и пр. Стоимость за упаковку саше – от 350 рублей.
7. Аквалор
Это средство представлено в форме спрея и в виде капель. По своей сути Аквалор – это раствор морской соли, соединенный с экстрактом ромашки аптечной и алоэ. Аквалор достаточно безопасен, разрешен к применению с момента рождения, может использоваться для профилактики ларингита, синусита и ринита.
Морская соль совместно с вытяжками из лекарственных трав снимает воспаление со слизистой, способствует отхождению слизи и очистке носовых ходов. При совместном применении с антибактериальными средствами, Аквалор усиливает их действие.
8. Ринопронт
Ринопронт – это аналог Синупрета в таблетках. Препарат оказывает следующее действие:
- устраняет отечность;
- снимает ощущение жжения и дискомфорта в носу;
- убирает головную боль;
- снижает гиперемию.
Эти свойства Ринопронта позволяют назначать препарат для лечения синусита и ринита у детей от 12-ти лет и взрослых. У препарата много противопоказаний, поэтому назначаться для лечения он должен только врачом.
Синупрет или синуфорте — что лучше
Синупрет, по сравнению с синуфорте, чаще используется в качестве монотерапии.
Нужно отметить, что курс лечения сунупретом дешевле, особенно в тех случаях, когда препарат используется длительно.
- Растительный состав (щавель, бузина, первоцвет, горечавка, вербена) синупрета обеспечивает выведение патологического секрета из околоносовых пазух.
- Препарат обладает антимикробным, противоотечным и иммуностимулирующим действием.
- Синупрет разрешен в педиатрии с двух лет. Драже рекомендуют давать только с 6 лет, так как дети в этом возрасте уже способны проглатывать таблетки.
Если рассматривать дозы препарата в форме драже, то обычно назначают по 1 драже трижды в день. Доза может быть увеличена до 6 драже для взрослых. Курс лечения обычно составляет 7–14 дней.
После приема препарата пациенты отмечают, что слизистая носа меньше пересыхает, уходит отечность и заложенность. Иногда пациенты предпочитают синупрет в каплях, их обычно назначают в педиатрии.
Иногда после приема синуфорте появляется тошнота, неприятные ощущения в желудке, зуд, одышка, другие симптомы. При появлении таких реакций препарат меняют на аналог.
Применение в педиатрии
Препараты Синупрет и Синуфронт показаны для лечения респираторных инфекций у детей разного возраста.
Синупрет – натуральный препарат на растительной основе, который эффективен при насморке, заложенности носа, гайморите, синусите и других заболеваниях верхних дыхательных путей. Он обладает выраженным муколитическим, секретомоторным и противовоспалительным действием.
Синуфронт является комбинированным препаратом, который также применяется в детской практике для лечения заболеваний верхних дыхательных путей. В его состав входят фенилэфрин – сосудосуживающий компонент, который сужает кровеносные сосуды и уменьшает отечность, и фенилпропаноламин – муколитический компонент, который усиливает слизеобразование и способствует разжижению секрета.
Оба препарата можно использовать у детей старше 1 года. Синупрет препоручается давать детям в возрасте от 1 года до 6 лет по 15 капель 3 раза в день, детям старше 6 лет – по 25 капель 3 раза в день. Синуфронт рекомендуется давать детям старше 6 лет по 5 мл сиропа 3 раза в день.
Перед применением препаратов следует проконсультироваться с педиатром и внимательно ознакомиться с инструкцией.
В чем суть
Препарат предназначен для лечения синусита. Синуситом называется воспаления слизистой в пазухах носа, которое может развиваться самостоятельно вследствие невылеченного ринита, быть последствием попадания в организм острой респираторной вирусной инфекции или появиться после лицевой травмы. Делится на хронический и острый. Острый протекает в более сложной форме, однако излечивается в течении 2 месяцев и, при надлежащем бережном отношении к организму, более не побеспокоит. Хронический лечится также долго, но способен вернуться при малейшей простуде. Лечением данного заболевания занимается врач-оториноларинголог
Очень важно своевременно обращаться к специалисту при возникновении тревожных симптомов. Самолечение способствует стремительному развитию болезни и возникновению в последствии серьезных осложнений, которые могут закончиться операционным вмешательством
Синусит бывает нескольких видов:
- Сфеноидит – довольно редкий. Воспаляются клиновидные пазухи;
- Этмоидит. Воспаление в пространстве между носом и черепом – пазуха решетчатой кости. При отсутствии квалифицированной медицинской помощи может перейти на глазницу и мозг.
- Фронтит. Воспалением поражена лобная пазуха. Протекает более тяжело.
- Гайморит. Воспаление верхнечелюстных (гайморовых) пазух.
Как работает Синупрет
Комбинированный препарат растительного происхождения воздействует на слизистую оболочку дыхательных путей. Его состав оказывает противоотечное действие, снижает вязкость секрета и снимает воспаление. Также он проявляет иммуномодулирующие свойства, восстанавливая способность слизистой к самоочищению. Тем самым получая преимущество перед лекарственными средствами, разжижающими и выводящими мокроту за счет воздействия на химическое и физическое свойство последней. Основа успеха – активные компоненты растительного комплекса.
Перед тем как продолжить, хотелось бы отметить, что «аналог» — это идентичный или соответствующий по определенным параметрам объект. Поэтому в перечне препаратов будут рассмотрены лишь похожие по параметрам. Ведь сам Синупрет уникален, так как производится по концепции Фитониринг, которая имеет запатентованные фармацевтические особенности. Все остальное по сути является дженериками (лекарствами, содержащими активный фармацевтический ингредиент, ранее запатентованный другой фирмой-производителем).
Противопоказан людям, имеющим заболевание пептической язвой или индивидуальную непереносимость компонентов, содержащихся в лекарстве.

Состав Синупрета
- Горечавки желтой корни. Основная роль – разжижение мокроты.
- Трава вербены. Обладает противовирусными и антисекреторными свойствами.
- Щавель. Обладает противовоспалительным, антибактериальным действием. Способствует укреплению иммунитета.
- Цветки первоцвета. Оказывают антимикробное, противовоспалительное, секретолитическое влияние на организм.
- Цветки бузины. Потогонное, снимающее отечность средство.
- Вспомогательные вещества: желатин, крахмал картофельный, стеариновая кислота, сорбитол, кремния диоксид.
Форма выпуска препарата
- Таблетки. До 6 лет не назначают. От 6 до 12 – 3 раза по 1 таблетке. Старше 12 – 3 раза по 2 штуки.
- Капли. Принимаются перорально, то есть в рот. Ни в коем случае не в нос. Взрослые пьют 50 капель без разведения. Детям 25, растворяют в воде. В составе подсластитель мальтит. Детям можно принимать препарат в таком виде с 2 лет.
- Сироп. Предназначен в основном для детей. Вишневый ароматизатор.
Синупрет: описание, показания и противопоказания
Препарат выпускается фармацевтической индустрией Германии в трех лекарственных формах: сироп, спиртовые капли и драже. Основу составляют природные компоненты: корни горечавки, цветки первоцвета и бузины, трава щавеля и вербены.

Благодаря сложному составу и свойствам входящих в лекарство биологически активных веществ, Синупрет оказывает широкий спектр эффектов:
Показания для назначения охватывают острые и хронические синуситы (в том числе гайморит, фронтит, этмоидит), для которых характерно образование вязкого секрета.
Для детей до 2 лет применятся сироп Синупрет, с 2-х лет разрешается назначение капель, в таблетках средство можно применять с 6-ти лет. Если у взрослого пациента имеются противопоказания к форме, содержащей спирт (лечение от алкоголизма и сама болезнь, беременность), то возможна замена на драже.
Синупрет – дешевые аналоги
Лекарство Синупрет не имеет идентичных аналогов, но все его можно заменить препаратами по сходному терапевтическому эффекту. Такие лекарства являются производством отечественных и иностранных фармацевтических компаний, имеют разную стоимость. Учитывая, что аналоги Синупрета имеют другой состав, принимать их можно только по рекомендации врача, тщательно изучая инструкцию по применению
Если человек ищет аналог дешевле, ему важно понимать, что низкая цена может отобразиться на качестве препарата
Многие ищут аналоги Синупрет в форме капель для носа или спреев. Однако таких препаратов на рынке нет. В основном спрей от насморка относится к симптоматическим препаратам, которые купируют симптомы ринита, но не оказывают влияние на организм изнутри. Именно поэтому сравнивать Синупрет с лекарствами в форме спрея нет необходимости. Применять подобные лекарства нужно в комплексе. Они хороши по совместимости, снимают симптомы болезни, ускоряют период выздоровления.
Синупрет или Тонзилгон – что лучше?
Тонзилгон – комплексный препарат на растительного происхождения, в составе которого содержатся вытяжки из листьев лечебных трав: одуванчик, кора дуба, хвощ, алтей. Препарат может применяться в комплексном лечении заболеваний ЛОР органов и системы дыхания вирусного или бактериального происхождения. Препарат обладает способностью воздействовать на кашлевой центр, уменьшает оттек тканей, повышает иммунитет. Тонзилгон обладает выраженным противовоспалительным, бактерицидным действием. В отличие от Синупрета, который больше действует на слизистую носа, Тонзилгон – лучше принимать при поражении органов дыхания. Совмещать оба препарата не рекомендуется.
Как показывает практика, Тонзилгон намного чаще вызывает аллергию, поэтому его с осторожностью нужно давать детям. Тонзилгон и Синупрет — похожи между собой, но это два разных препараты, которые не только имеют разный состав, но и принцип действия
Стоимость Тонзилгон составляет от 280 рублей за капли, и 270 рублей – драже.
Циннабсин или Синупрет – что выбрать?
Близкий аналог Синупрета по терапевтическому действию — таблетки Циннабсин, которые относятся к гомеопатии, применяются для лечения заболеваний носа, горла. Препарат имеет хорошую переносимость, не имеет противопоказаний, может назначаться маленьким детям. Таблетки Циннабсин часто применяются в терапии заболеваний поражающих придаточные пазухи носа: синусит, фронтит, гайморит. Прием лекарства позволяет облегчать носовое дыхание, снимать оттек слизистой, нейтрализовать воспалительные процессы. Эффект от лечения будет присутствовать уже через 4 – 7 дней. В отличие от Синупрета, принимать Циннабсин нужно намного дольше. Цена Циннабсина — 590 рублей за упаковку из 100 таблеток.
Дешевые Аналоги синуфорте — список с ценами
Большинство пациентов хотят найти доступный аналог, цена которого будет в адекватных пределах. Конечно, что лучше выбрать, какой препарат будет уместнее, виднее врачу. Поэтому дешево – не всегда эффективно.
Аналоги дешевле все же востребованы больше, чем дорогие препараты, следовательно, давайте рассмотрим их список с ценами:
- гайморин микс – российский препарат, цена около 140 рублей;
- афлубин-назе – австрийское средство, цена около 340 рублей;
- гайморин –украинское средство, цена – 210 руб.;
- пиновит (Украина) – 120 руб.;
- целитель (Украина) – 140 рублей.
Гайморит микс

Средство эффективно очищает носовые пазухи от «цветных» соплей с неприятным запахом. Желтые и желто-зеленые сопли – прямое показание к использованию данного средства.
Гайморит микс не провоцирует побочные реакции, применяется в педиатрии и при беременности с разрешения врача, следовательно, является альтернативой для замены синуфорте.
Афлубин-Назе (назальный спрей)
На фоне применения афлубин-назе улучшается общее состояние пациентов, проходит отечность в носовой полости, патогенный секрет быстрее покидает околоносовые пазухи (синусы). Такой терапевтический эффект достигается за счет выраженного противовоспалительного и иммуностимулирующего действия гомеопатического состава рассматриваемого препарата.
Курс лечения колеблется от 7 до 30 дней. Назначают препарат только после 12 лет. Впрыскивания проводят до 4 раз в день, вводя в каждую ноздрю по две дозы. Максимальная суточная доза – 16 впрыскиваний в каждую ноздрю (8 раз в сутки).
Побочных эффектов практически нет, в инструкции по применению есть предупреждение о возможном слюнотечении.
Афлубин-назе не назначают при гипертиреозе и непереносимости состава препарата. Беременность не является противопоказанием.
Гайморин
В остром периоде болезни гайморин назначают до 6 раз в день по 5 гранул. Затем переходят на трехкратное и однократное применение. Длительность терапии до трех месяцев.
Пиновит (Украина)

Такой состав быстро снимает отечность, воспаление, разжижает вязкую слизь, оказывает умеренное противомикробное действие. Пиновит пагубно действует и на грибковую микрофлору.
Согласно инструкции по применению пиновит используют при следующих патологиях: воспалительные процессы носоглотки, риниты вирусной и бактериальной природы, ларинготрахеит, ринофарингит. Беременность и период лактации не являются противопоказанием к применению.
- Закапывания всегда начинают с ударных доз, затем ежедневно увеличивают время между введением пиновита.
- В первый день болезни капли закапывают до 6 раз в день. В каждую ноздрю вводят по 2–3 капли раствора.
- Для детей, которым уже исполнилось два года, режим дозирования показан следующий – по 1–2 капли трижды в день, или как назначит специалист. Длительность терапии длится около 7 дней.
Побочные реакции чаще появляются у людей склонных к аллергическим реакциям. Иногда наблюдаются следующие симптомы: жжение, зуд, неприятные ощущения в носу, высыпания на коже, крапивница, ангионевротический отек.
Капли не назначают при: аллергическом рините и непереносимости состава пиновита. При появлении негативных симптомов следует провести замену на другое лекарственное средство схожее по терапевтическому эффекту.
Целитель (спрей для носа)
Еще один популярный украинский препарат, включающий 9 натуральных компонентов. Среди них есть вещества растительного происхождения, а также прополис. В составе средства есть цикламен, поэтому целитель и синуфорте можно считать частичными аналогами.
Средство используется для взрослых и детей. Состав препарата обладает выраженным антибактериальным и противовоспалительным действием. Помимо этого, хорошо снимает отечность и дренирует пазухи.
По отзывам пациентов и врачей благодаря целителю удается не доводить ситуацию до такой неприятной манипуляции, как прокол.
- Длительность лечения зависит от тяжести воспалительного процесса в околоносовых пазухах, в среднем это неделя. Спрей вводят по 1–2 впрыскиванию до трех раз в день.
- Противопоказания: аллергический ринит, новообразования. Препарат может использоваться с профилактической целью.
Помимо представленных аналогов синуфорте есть и другие препараты, они дороже, но заслуживают внимания.
Состав и действующие вещества препаратов
Синупрет и Синуфронт — два эффективных препарата, использующихся при лечении насморка. Они содержат различные действующие вещества, которые помогают справиться с симптомами и улучшить общее состояние пациента.
Синупрет содержит экстракты из различных растений, таких как вероника лекарственная, ястык курительный, тутовник шелковистый и другие. Эти растения обладают противовоспалительными, успокаивающими и муколитическими свойствами, что позволяет расслабить слизистые оболочки и облегчить отхождение слизи из носа.
Синуфронт, в свою очередь, содержит главное действующее вещество — оксиметазолин. Он является сосудосуживающим веществом, которое уменьшает отек слизистой оболочки носа и улучшает проходимость носовых ходов. Это позволяет уменьшить заложенность носа и облегчить дыхание.
Оба препарата имеют свои преимущества и могут быть эффективны при лечении насморка. Выбор между ними зависит от индивидуальных предпочтений и особенностей организма каждого пациента
Важно проконсультироваться с врачом и выбрать подходящий препарат, учитывая возможные побочные эффекты и противопоказания
Группы антибиотиков, применяемые при гайморите
Для устранения первопричины воспалительного процесса, поражающего слизистую оболочку гайморовых пазух, могут быть использован следующий список антибактериальных препаратов:
- Пенициллинового ряда – хорошо переносятся пациентами, используются при неосложненных формах гайморита, в особенности, при лечении младших возрастных групп. Врач может рекомендовать использование Ампициллина, Амоксициллина, Амоксиклава, Флемоксина солютаба. Среди недостатков отмечают малую эффективности при воздействии на возбудителей, нечувствительных к пенициллину. Суточную дозировку Амоксициллина рекомендовано распределять на несколько приемов, таблетки используют после основного приема пищи, не более 1 недели.
- Лекарства из группы макролидов назначают при неэффективности других групп антибиотиков и при непереносимости пенициллинов. Одним из препаратов выбора могут стать средства на основе азитромицина, кларитромицина, мидекамицина.
- Могут быть использованы лекарства, которые относятся к антибактериальной группе фторхинолонов: на основе левофлоксацина, офлоксацина, моксифлоксацина. Это наиболее сильные и самые эффективные представители группы антибиотиков, которые используют как при остром, так и при хроническим течении гайморита.
- Лекарства цефалоспоринового ряда используют при тяжелом течении патологического процесса. Рассматривают возможность применения Цефтриаксона, Цефотаксима, Цефуроксима, Цефподоксима. Иногда врачи принимают решение о комбинировании сразу нескольких цефалоспоринов (Цефиксим+Цефподоксим). Подобное сочетание активных веществ оказывает действенный эффект на большинство патогенных микроорганизмов, провоцирующих развитие патологического процесса.
Лечение гайморита антибиотиками из группы фторхинолонов не рекомендовано детям и подросткам из-за высокого риска развития необратимых процессов, поражающих хрящевые ткани. Все препараты выпускаются в таблетках и этого списка бывает достаточно чтобы избавиться как от острой так и от хронической формы заболевания.
Опасность самостоятельного лечения
Познакомившись с информацией о том, какой антибиотик лучше при гайморите, рекомендовано воздерживаться от самолечения.
Назначение любого препарата требует проведения батереологического посева слизи из придаточных пазух на питательные среды, для выявления чувствительности к тому или иному антибактериальному средству.
Если препараты использовать самостоятельно, лечение будет неэффективным, к тому же велик шанс ошибиться и у бактерий разовьется резистентность (устойчивость) к действующему веществу.
Особенно опасно это в случае с фторхинолонами — ведь только они действуют на палочку Коха. Если больной скрытый ее носитель, а бактерии выработали устойчивость к единственному лекарству — это будет означать смертный приговор для пациента.
Синупрет или геломиртол что лучше
При анализе эффекта двух аналогичных препаратов пациенты часто сталкиваются с выбором, который поможет ускорить процесс выздоровления. Следует отметить, что геломирол представляет собой схожий препарат, произведенный в Германии, на основе растительных компонентов, с разжижающим действием, рекомендуемый при синусите. Отличие заключается в том, что препарат геломиртол содержит в своем составе растительные экстракты и производится в специальных капсулах, наполненных маслянистой жидкостью. По отзывам пациентов, у препарата также имеется несколько недостатков:
- Ограничения в применении во время беременности и грудного вскармливания;
- Невозможность использования при наличии камней в желчном пузыре;
- Не рекомендуется при заболеваниях почек;
- Необходимость регулярного применения;
- Более высокая стоимость по сравнению со схожими препаратами, такими как синупрет.
При одинаковых условиях синупрет является наиболее предпочтительным лекарственным средством из-за его более широкого спектра действия.
Принципы действия
Синупрет и синуфронт — это два разных препарата, которые применяются для лечения насморка и синусита. Они имеют разные принципы действия и состав, поэтому выбор между ними зависит от конкретной ситуации и рекомендаций врача.
Синупрет — это комбинированный фитопрепарат, содержащий экстракты медуницы, желтого цветка, алтейки, вербены и эхинацеи. Его действие основано на стимуляции секреции слизи, улучшении оттока и очищении дыхательных путей. Кроме того, Синупрет обладает противовоспалительным и муколитическим действием. Препарат принимается в виде таблеток или капель, и рекомендуется для лечения острого и хронического риносинусита. Он помогает устранить заложенность носа, улучшить отток секрета и снизить воспаление в синусах.
Синуфронт — это противосинуситный препарат, основным действующим веществом которого является фенилэфрин. Он сужает сосуды слизистой оболочки носа, уменьшая отек и устраняя заложенность. Кроме того, Синуфронт обладает противовоспалительным эффектом, снижает секрецию слизи и способствует улучшению дыхания. Препарат доступен в виде спрея или капель. Синуфронт эффективен при острой и хронической форме синусита, а также при аллергическом и вазомоторном насморке.
В итоге, выбор между Синупретом и Синуфронтом зависит от конкретных симптомов, диагноза и рекомендаций врача. Оба препарата эффективны и могут помочь в лечении насморка и синусита, но для достижения наилучшего результата необходимо правильно подобрать средство и соблюдать рекомендации по его применению.
Аналоги для промывания носа
Заменители препарата Синупрет могут выпускаться не только в форме спреев, капель и таблеток, но и в виде растворов для промывания носа. При скоплении гноя и слизи в пазухах носа может быть выписано средство Долфин. В его основе – гранулы морской соли и емкость со специальной насадкой для промывания.
Гранулы разводят водой и промывают нос до 3-х раз в день. Такая процедура показана при гайморите, синусите, рините (в том числе аллергическом). Проведенная манипуляция способствует восстановлению носового дыхания. Цена на Долфин, как на аналог, соизмерима со стоимостью Синупрета.
Развитие фармакологии не стоит на месте, на рынке постоянно появляются новые эффективные препараты и аналоги. Заменить Синупрет достаточно просто, но сделать это должен врач, с учетом всех особенностей состояния здоровья пациента и нюансов использования каждого из препаратов схожего действия.
Источники:
Видаль: https://www.vidal.ru/drugs/sinupret__762 ГРЛС: https://grls.rosminzdrav.ru/Grls_View_v2.aspx?routingGuid=527345d1-cbad-4f00-a4bb-0f236eb64ecb&t=
Нашли ошибку? Выделите ее и нажмите Ctrl + Enter



























